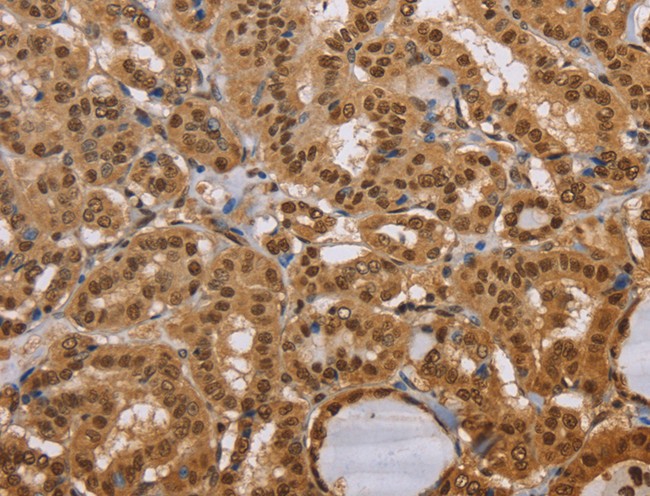
product-image-AAA166758_IHC11.jpg

Nepsilon-(carboxyethyl) lysine (CEL) ELISA Kit | CEL elisa kit
OxiSelect Nepsilon-(carboxyethyl) lysine (CEL) Competitive ELISA Kit
Reactivity
Nepsilon-(carboxyethyl) lysine
Synonyms
Nepsilon-(carboxyethyl) lysine (CEL); N/A; OxiSelect Nepsilon-(carboxyethyl) lysine (CEL) Competitive ELISA Kit; CEL elisa kit
Reactivity
Nepsilon-(carboxyethyl) lysine
Detection Method
Colorimetric
Notes
Provides rapid detection and quantitation of CEL protein adducts
Perform up to 5x96 assays, including standard curve and unknown protein samples
Will not cross react with CML protein adducts
Perform up to 5x96 assays, including standard curve and unknown protein samples
Will not cross react with CML protein adducts
Related Product Information for CEL elisa kit
Background: The non-enzymatic reaction of reducing carbohydrates with lysine side chains and N-terminal amino groups of macromolecules (proteins, phospholipids and nucleic acids) is called the Maillard reaction or glycation. The products of this process, termed advanced glycation end products (AGEs), adversely affect the functional properties of proteins, lipids and DNA. Tissue levels of AGE increase with age and the formation of AGEs is predominantly endogenous, though these products can also be derived from exogenous sources such as food and tobacco smoke. AGE modification of proteins can contribute to the pathophysiology of aging and long-term complications of diabetes, atherosclerosis and renal failure. AGEs also interact with a variety of cell-surface AGE-binding receptors (RAGE), leading either to their endocytosis and degradation or to cellular activation and pro-oxidant or proinflammatory events. Although several AGE structures have been reported, it was demonstrated that Nepsilon-(carboxymethyl) lysine (CML) and Nepsilon-(carboxyethyl) lysine (CEL) are the major antigenic AGE structures. Next to glucose, reactive di-carbonyl compounds such as methylglyoxal are major precursors in the formation of cellular and extracellular AGEs. Methylglyoxal reacts with lysine residues to form CEL. CEL concentration is increased in patients who have diabetes with complications. OxiSelect™ Nepsilon-(carboxyethyl) lysine (CEL) ELISA Kit provides rapid detection and quantitation of CEL protein adducts. The quantity of CEL adduct in protein samples is determined by comparing its absorbance with that of a known CEL-BSA standard curve. Each kit provides sufficient reagents to perform up to 96 assays, including standard curve and unknown protein samples.
Principle of the Assay: First, a CEL conjugate is coated on the ELISA plate. The unknown CEL protein samples or CELBSA standards are then added to the CEL conjugate preabsorbed plate. After a brief incubation, the anti-CEL monoclonal antibody is added, followed by an HRP conjugated secondary antibody. The content of CEL protein adducts in unknown samples is determined by comparison with the predetermined CEL-BSA standard curve. Despite the structure similarity between CEL and CML, the anti-CEL specific antibody in the OxiSelect™ CEL ELISA Kit will not cross react with CML protein adducts.
Principle of the Assay: First, a CEL conjugate is coated on the ELISA plate. The unknown CEL protein samples or CELBSA standards are then added to the CEL conjugate preabsorbed plate. After a brief incubation, the anti-CEL monoclonal antibody is added, followed by an HRP conjugated secondary antibody. The content of CEL protein adducts in unknown samples is determined by comparison with the predetermined CEL-BSA standard curve. Despite the structure similarity between CEL and CML, the anti-CEL specific antibody in the OxiSelect™ CEL ELISA Kit will not cross react with CML protein adducts.
Product Categories/Family for CEL elisa kit
Customer Reviews
Loading reviews...
Share Your Experience
Similar Products
Product Notes
The Nepsilon-(carboxyethyl) lysine CEL (Catalog #AAA44702) is an ELISA Kit and is intended for research purposes only. The product is available for immediate purchase. The AAA44702 ELISA Kit recognizes Nepsilon-(carboxyethyl) lysine CEL. It is sometimes possible for the material contained within the vial of "Nepsilon-(carboxyethyl) lysine (CEL), ELISA Kit" to become dispersed throughout the inside of the vial, particularly around the seal of said vial, during shipment and storage. We always suggest centrifuging these vials to consolidate all of the liquid away from the lid and to the bottom of the vial prior to opening. Please be advised that certain products may require dry ice for shipping and that, if this is the case, an additional dry ice fee may also be required.Precautions
All products in the AAA Biotech catalog are strictly for research-use only, and are absolutely not suitable for use in any sort of medical, therapeutic, prophylactic, in-vivo, or diagnostic capacity. By purchasing a product from AAA Biotech, you are explicitly certifying that said products will be properly tested and used in line with industry standard. AAA Biotech and its authorized distribution partners reserve the right to refuse to fulfill any order if we have any indication that a purchaser may be intending to use a product outside of our accepted criteria.Disclaimer
Though we do strive to guarantee the information represented in this datasheet, AAA Biotech cannot be held responsible for any oversights or imprecisions. AAA Biotech reserves the right to adjust any aspect of this datasheet at any time and without notice. It is the responsibility of the customer to inform AAA Biotech of any product performance issues observed or experienced within 30 days of receipt of said product. To see additional details on this or any of our other policies, please see our Terms & Conditions page.Item has been added to Shopping Cart
If you are ready to order, navigate to Shopping Cart and get ready to checkout.